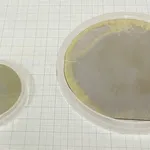
Cropped 4 Inch Substrate Comparison Image FINAL

424Wire Stories
424Wire StoriesCoeur Reports Second Quarter 2023 Results
Rochester Expansion Near Completion CHICAGO–(BUSINESS WIRE)–Coeur Mining, Inc. (“Coeur†or the “Companyâ€) (NYSE: CDE) today reported second quarter 2023 financial results, including...

 478Wire Stories
478Wire StoriesMakeMyTrip Limited Announces Details of its Annual Shareholders Meeting
GURUGRAM, India & NEW YORK–(BUSINESS WIRE)–#AnnualShareholdersMeeting—MakeMyTrip Limited (NASDAQ: MMYT) (the “Companyâ€), India’s leading online travel company, announced today that the annual meeting...

 461Wire Stories
461Wire StoriesBYD Rolled Off Its 5 Millionth New Energy Vehicle
SHENZHEN, China–(BUSINESS WIRE)–BYD, the world’s leading manufacturer of new energy vehicles and power batteries, rolled off its 5 millionth new energy vehicle...

 595Wire Stories
595Wire StoriesIndonesia Construction Industry Report 2023: Industry Poised for 4.5% Growth in 2024 and 6.4% for 2025-2027 – Focus on EV and Infrastructure Projects – ResearchAndMarkets.com
DUBLIN–(BUSINESS WIRE)–The “Indonesia Construction Market Size, Trend Analysis by Sector (Commercial, Industrial, Infrastructure, Energy and Utilities, Institutional and Residential) and Forecast, 2023-2027”...

 436Wire Stories
436Wire StoriesOKI Releases Issue 241 of the OKI Technical Review Featuring “OKI’s Contributions toward Green Society and Environmentâ€
TOKYO–(BUSINESS WIRE)–OKI (TOKYO:6703) has released Issue 241 of the OKI Technical Review (Note 1). The theme of this special feature is “OKI’s...

 456Wire Stories
456Wire StoriesNexon Releases Earnings for Second Quarter 2023
Record-Breaking Second Quarter Revenue Up 12% YoY Performance Driven by FIFA ONLINE 4, FIFA MOBILE, Wars of Prasia, HIT2, and Blue Archive...

 478Wire Stories
478Wire StoriesChingari’s Integration with Aptos Blockchain Leads to Record Growth in User Activity
The integration marks a significant milestone in the adoption of Web3 social media, with Chingari’s user base expanding at unprecedented rates on...

 501Wire Stories
501Wire StoriesCrystal IS and Asahi Kasei Announce First 4-inch Aluminum Nitride Substrate
Crystal IS has achieved 4-inch (100 mm) diameter bulk aluminum nitride substrate GREEN ISLAND, N.Y.–(BUSINESS WIRE)–Crystal IS, an Asahi Kasei company, today...

 509Wire Stories
509Wire StoriesTransphorm’s GaN First to Hit Short Circuit Robustness Milestone Key to Motor Drive Applications
Achieved in Collaboration with Yaskawa Electric Corporation, Capability Leverages the Fundamental Advantages of Transphorm’s Normally-Off Platform GOLETA, Calif.–(BUSINESS WIRE)–$TGAN #5G—Transphorm, Inc. (Nasdaq:...

 545Wire Stories
545Wire StoriesAnnalise Enterprise Scores Big with Series of Regulatory Clearances
Annalise.ai’s solutions are now available for clinical use in more than 40 countries with the latest clearances from the EU and Singapore....